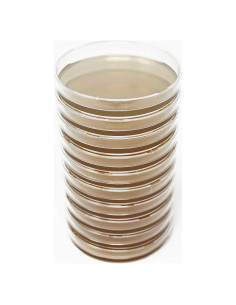
Placas de Agar de Extracto de Malta MEA EZ BioResearch - 10 Unidades
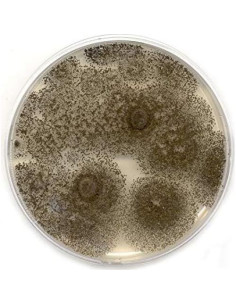
Placas de Agar de Extracto de Malta MEA EZ BioResearch - 10 Unidades 2

Carrito
No hay más artículos en su carrito
Características destacadas
- Nuestra levadura nutricional contiene minerales que ocurren naturalmente en cada porción. Además, nuestras tabletas están ligeramente saborizadas con vainilla, por lo que tienes la opción de masticar antes de tragar, pero ten cuidado, a algunos clientes realmente no les gusta el sabor. Incluye 270 tabletas.
- Nuestras instalaciones de fabricación de última generación están ubicadas en los EE. UU. y están compuestas por individuos altamente capacitados que formulan productos superiores. Al estar certificadas bajo las leyes y regulaciones de EE. UU. (Certificación GMP), estas instalaciones no hacen concesiones en cuanto a limpieza y control de calidad.
- Lo sentimos, pero si estás buscando barato, estás en el lugar equivocado. Buscamos en todas partes, tanto a nivel nacional como internacional, para proporcionar ingredientes de alta calidad por los que tu cuerpo te lo agradecerá. Desafortunadamente, obtener los mejores ingredientes de granjas nacionales e internacionales puede tener un costo más alto de lo normal. Si la calidad, la satisfacción y los resultados son esenciales para ti, ¡estás en el lugar correcto!
- También conocido como El Doctor del Conocimiento, el Dr. Berg ha pasado la mayor parte de su vida investigando y proporcionando soluciones naturales a problemas de salud cotidianos. Esta extensa investigación y miles de horas trabajando con pacientes son lo que nos distingue de otras marcas, ya que nos ha permitido crear mezclas exclusivas que no puedes encontrar en ningún otro lugar.
- Si por alguna razón no estás satisfecho con los resultados que experimentas dentro de los primeros 30 días, ¡estamos felices de ofrecerte un reembolso completo! Envíanos un mensaje y el reembolso será procesado siempre que se solicite dentro de los 30 días posteriores a la compra.
Especificaciones técnicas
- Fabricante: The Health & Wellness Inc.
- Departamento: unisex-adulto
- País de origen: EE. UU.
- Está descontinuado por el fabricante: No
- Peso: 0.33 kg
- Dimensiones: Ancho: 9.5 cm, Alto: 7.5 cm, Profundidad: 7.3 cm